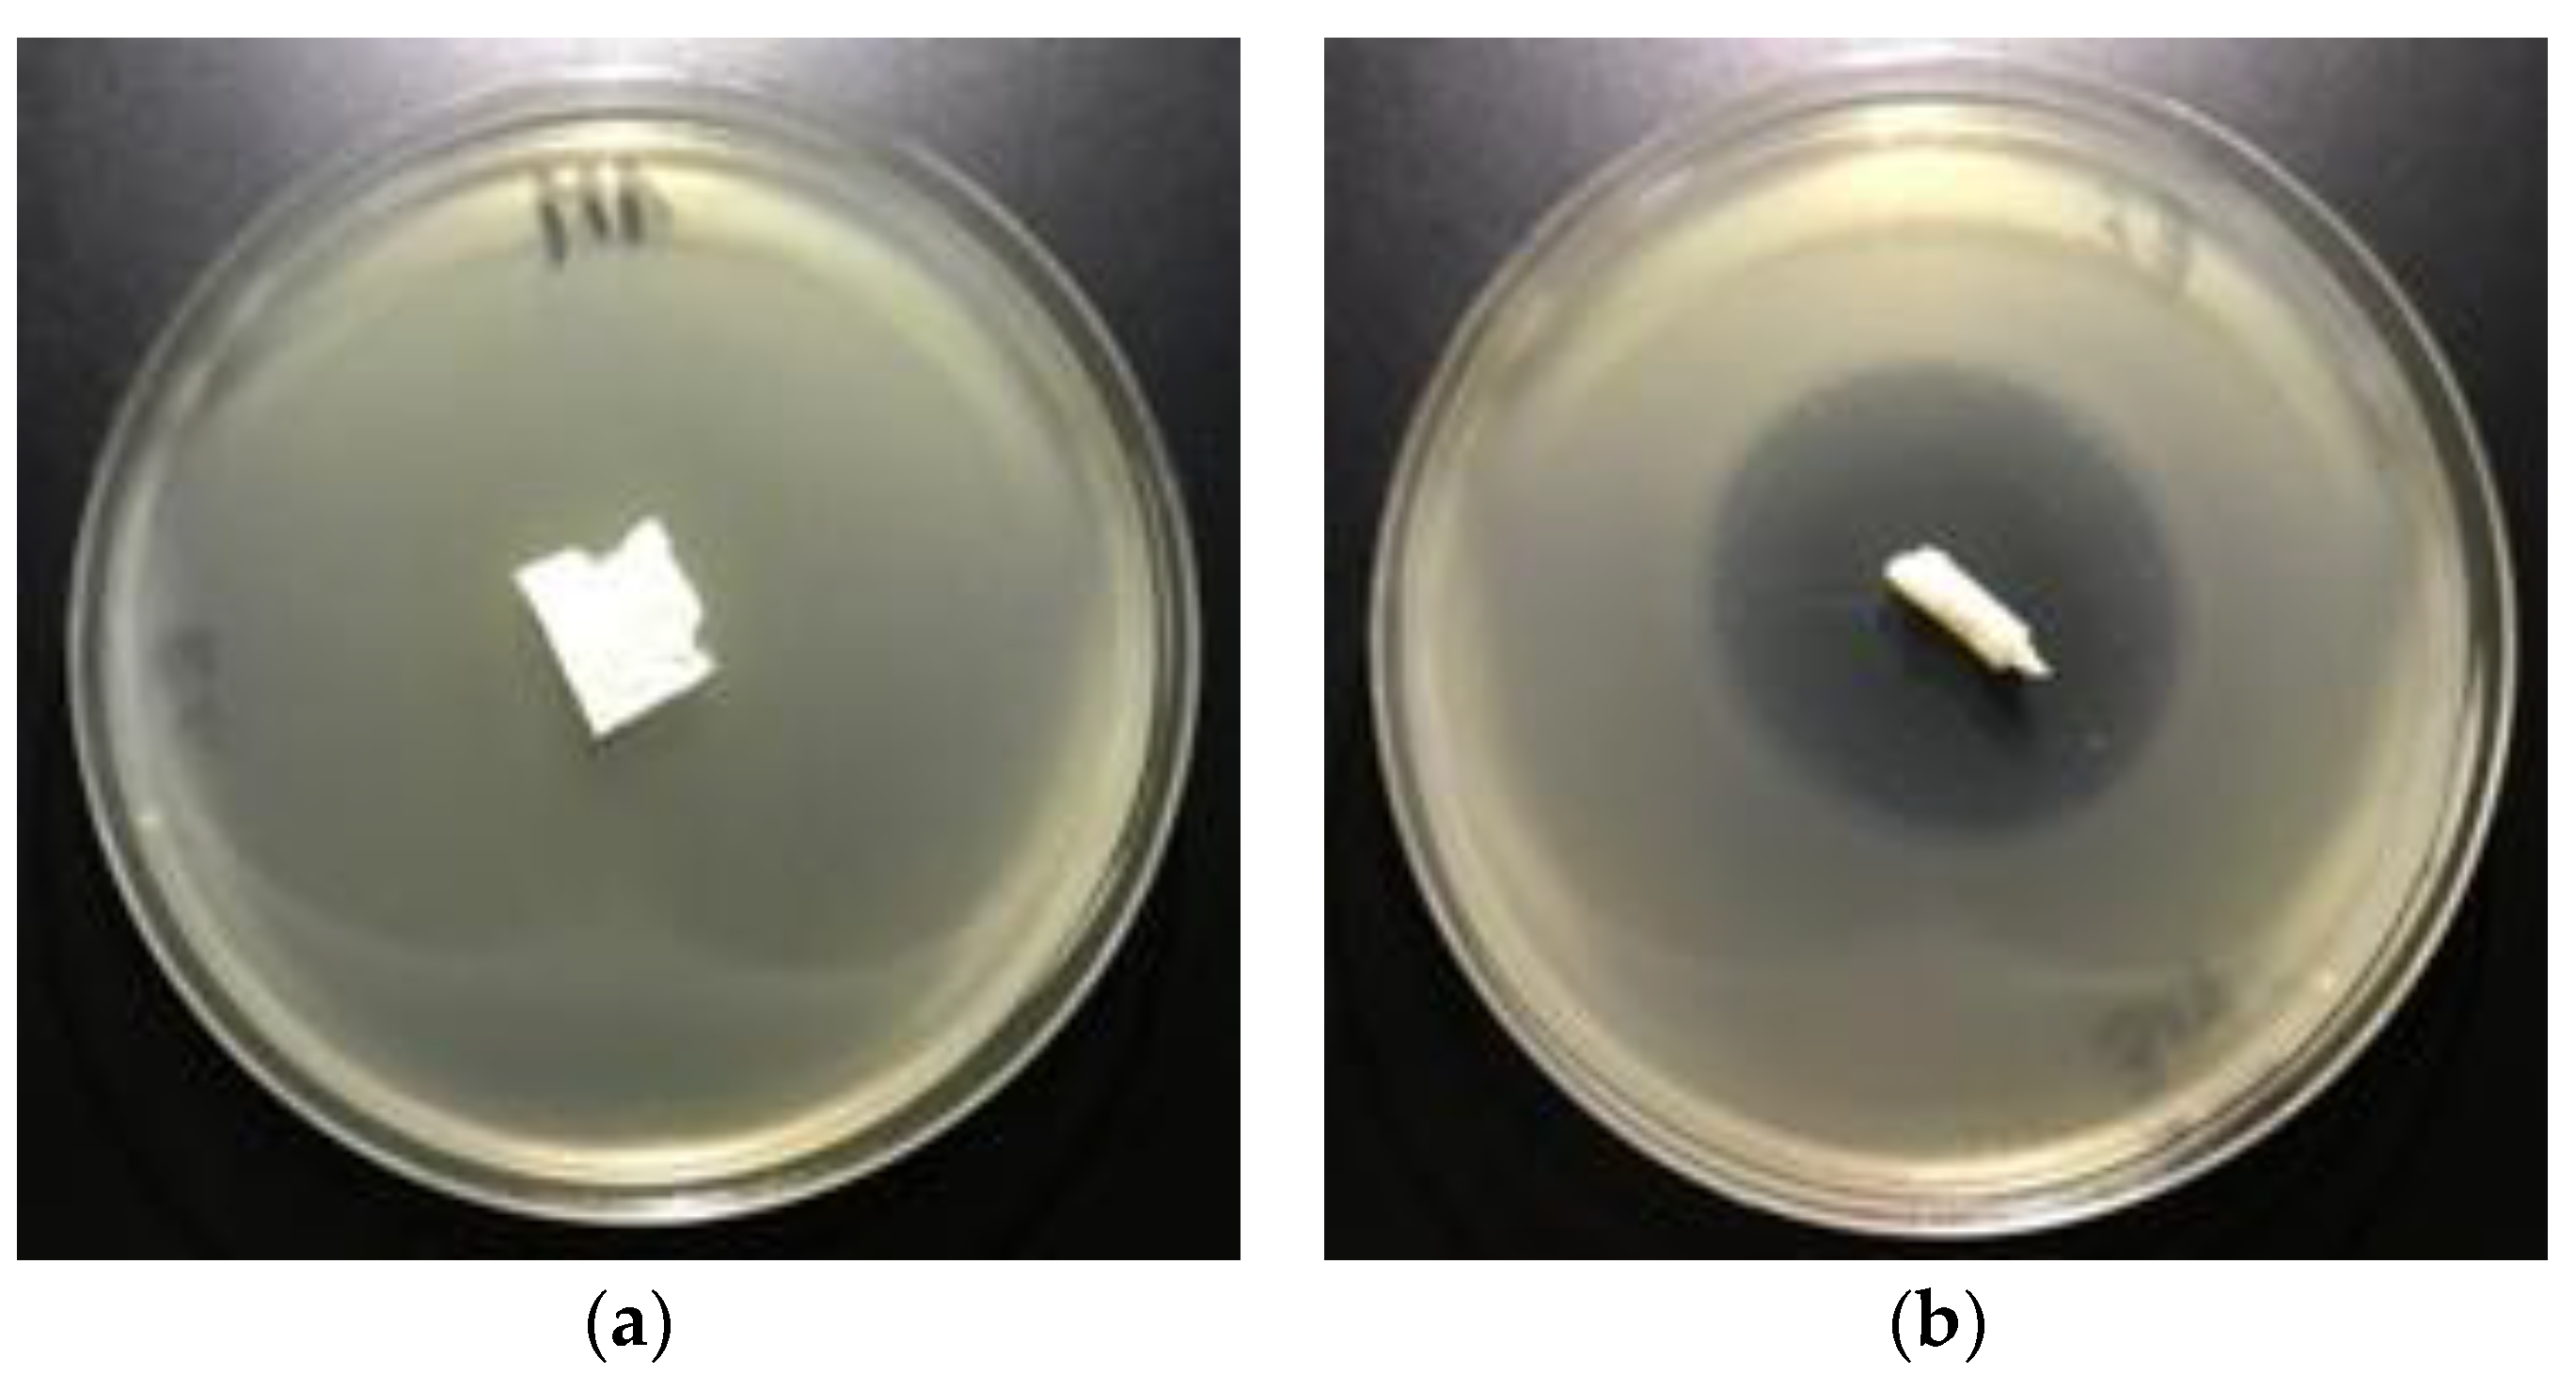
Polymers 12 00768 g008a Polymers 12 00768 g008a
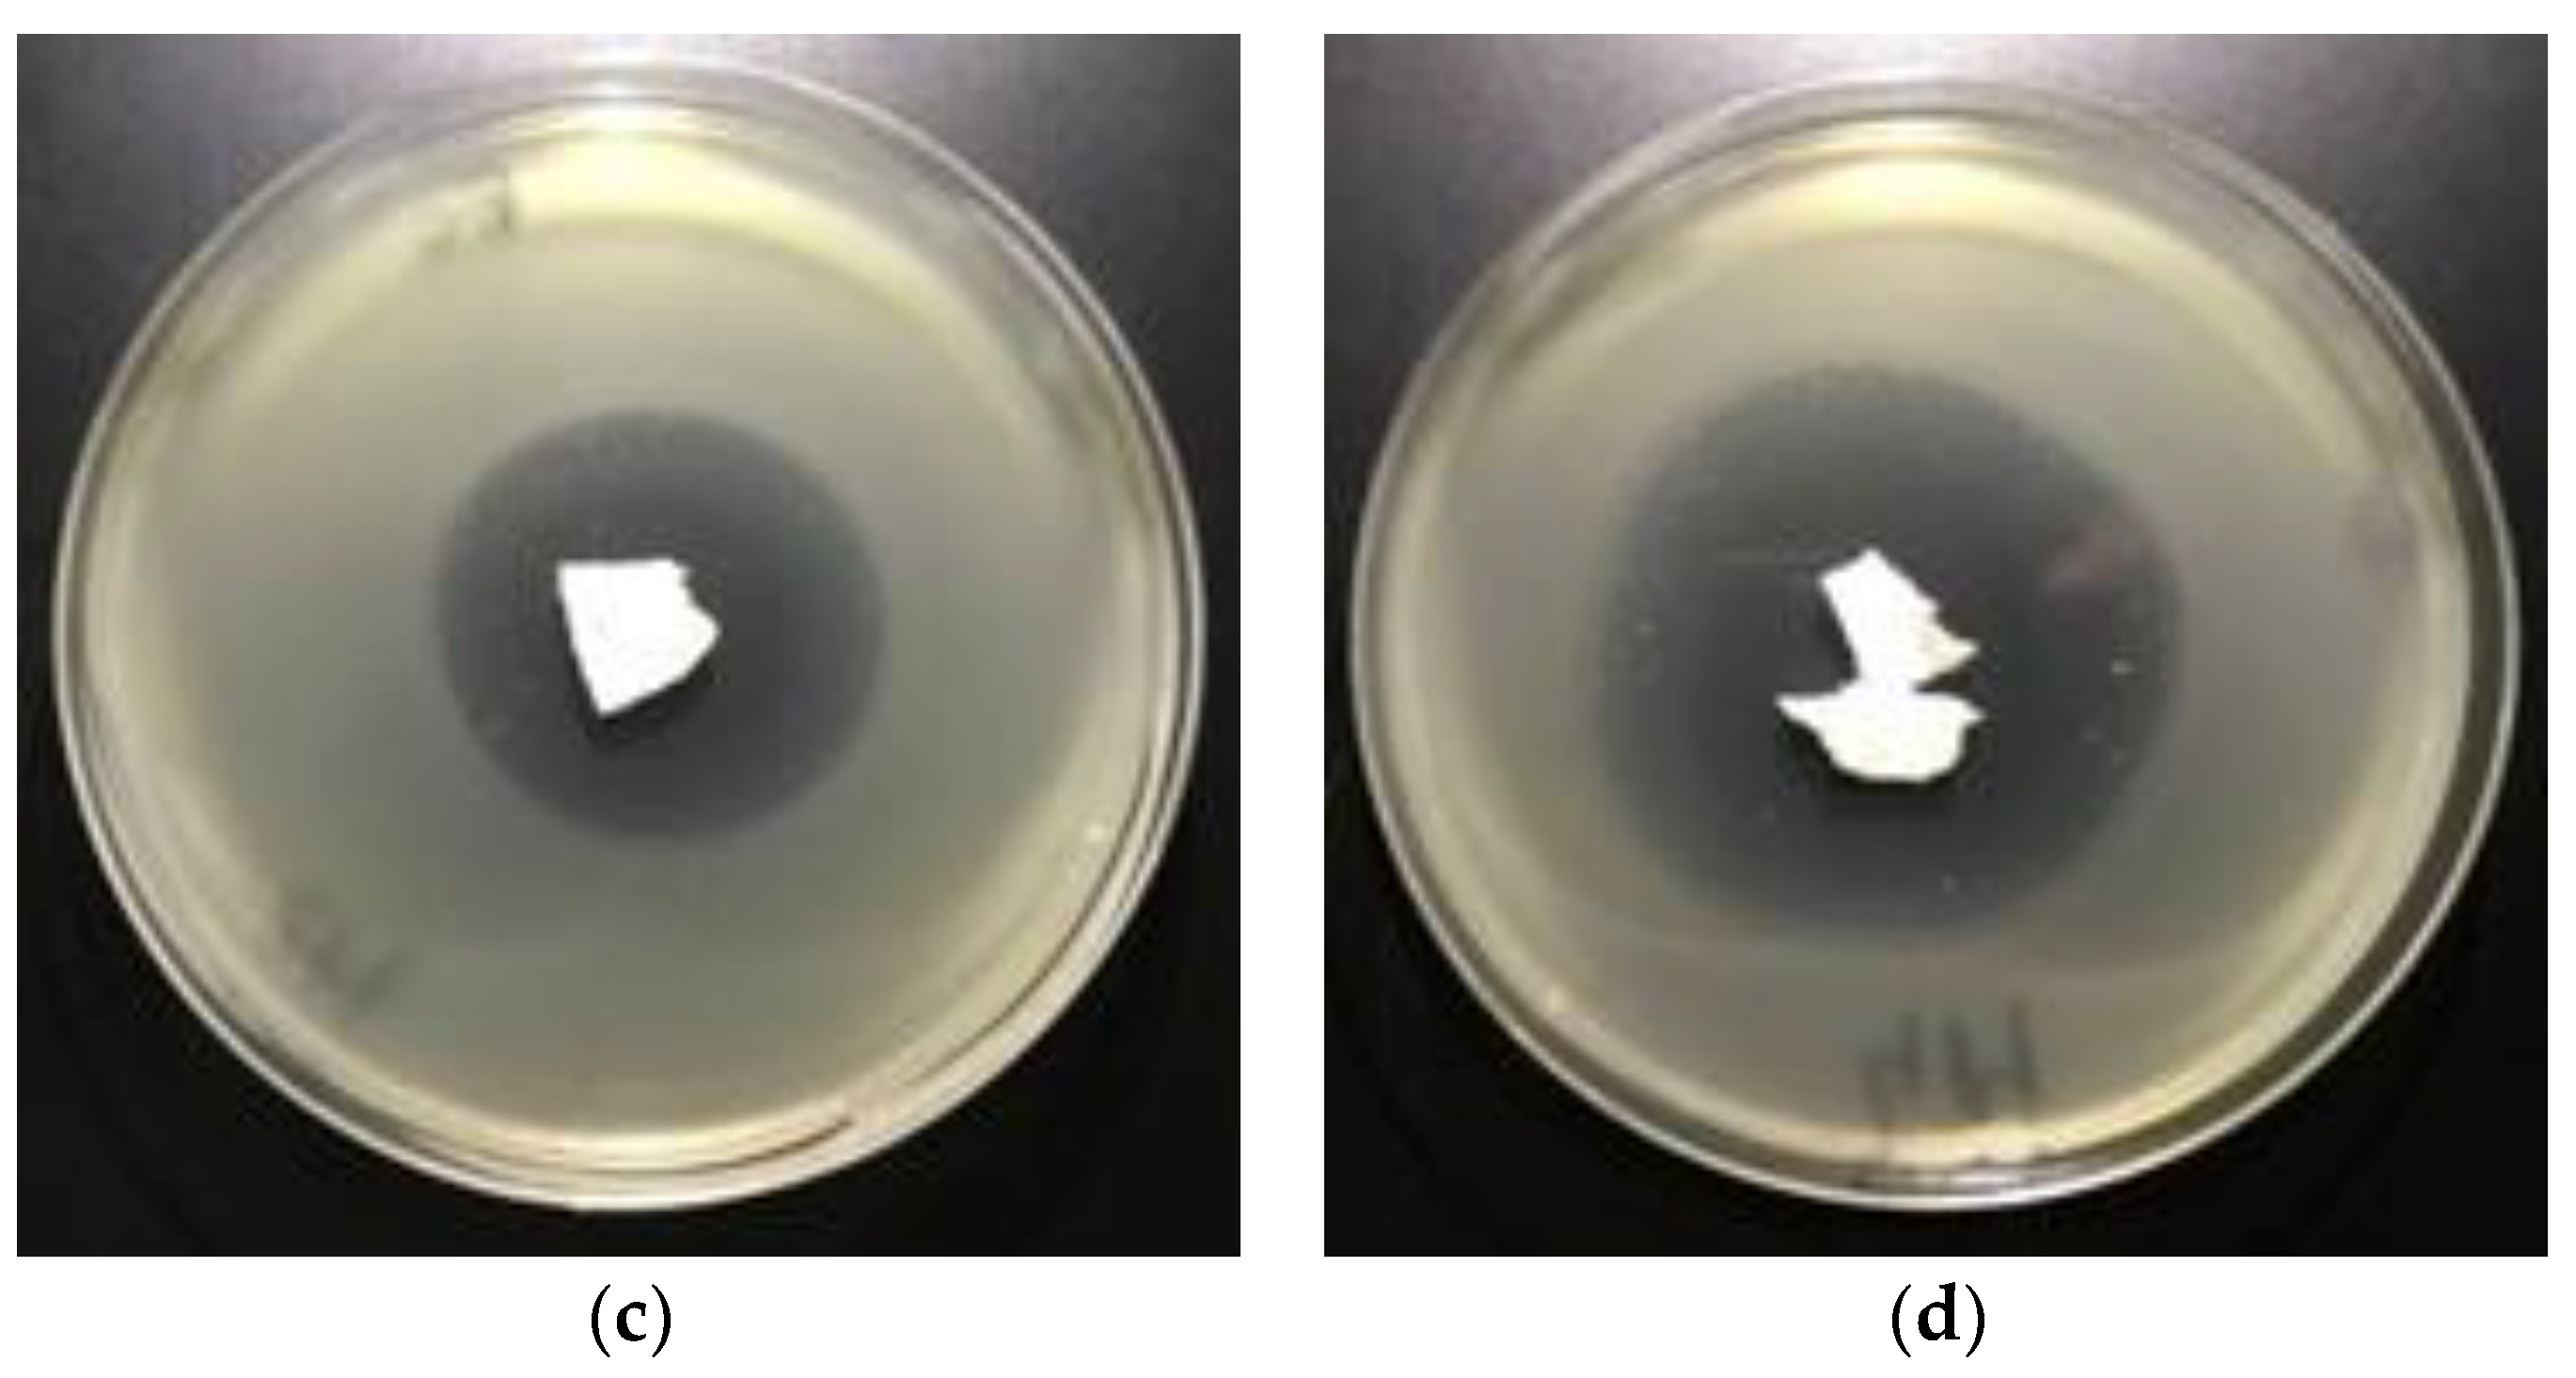
Polymers 12 00768 g008b Polymers 12 00768 g008b
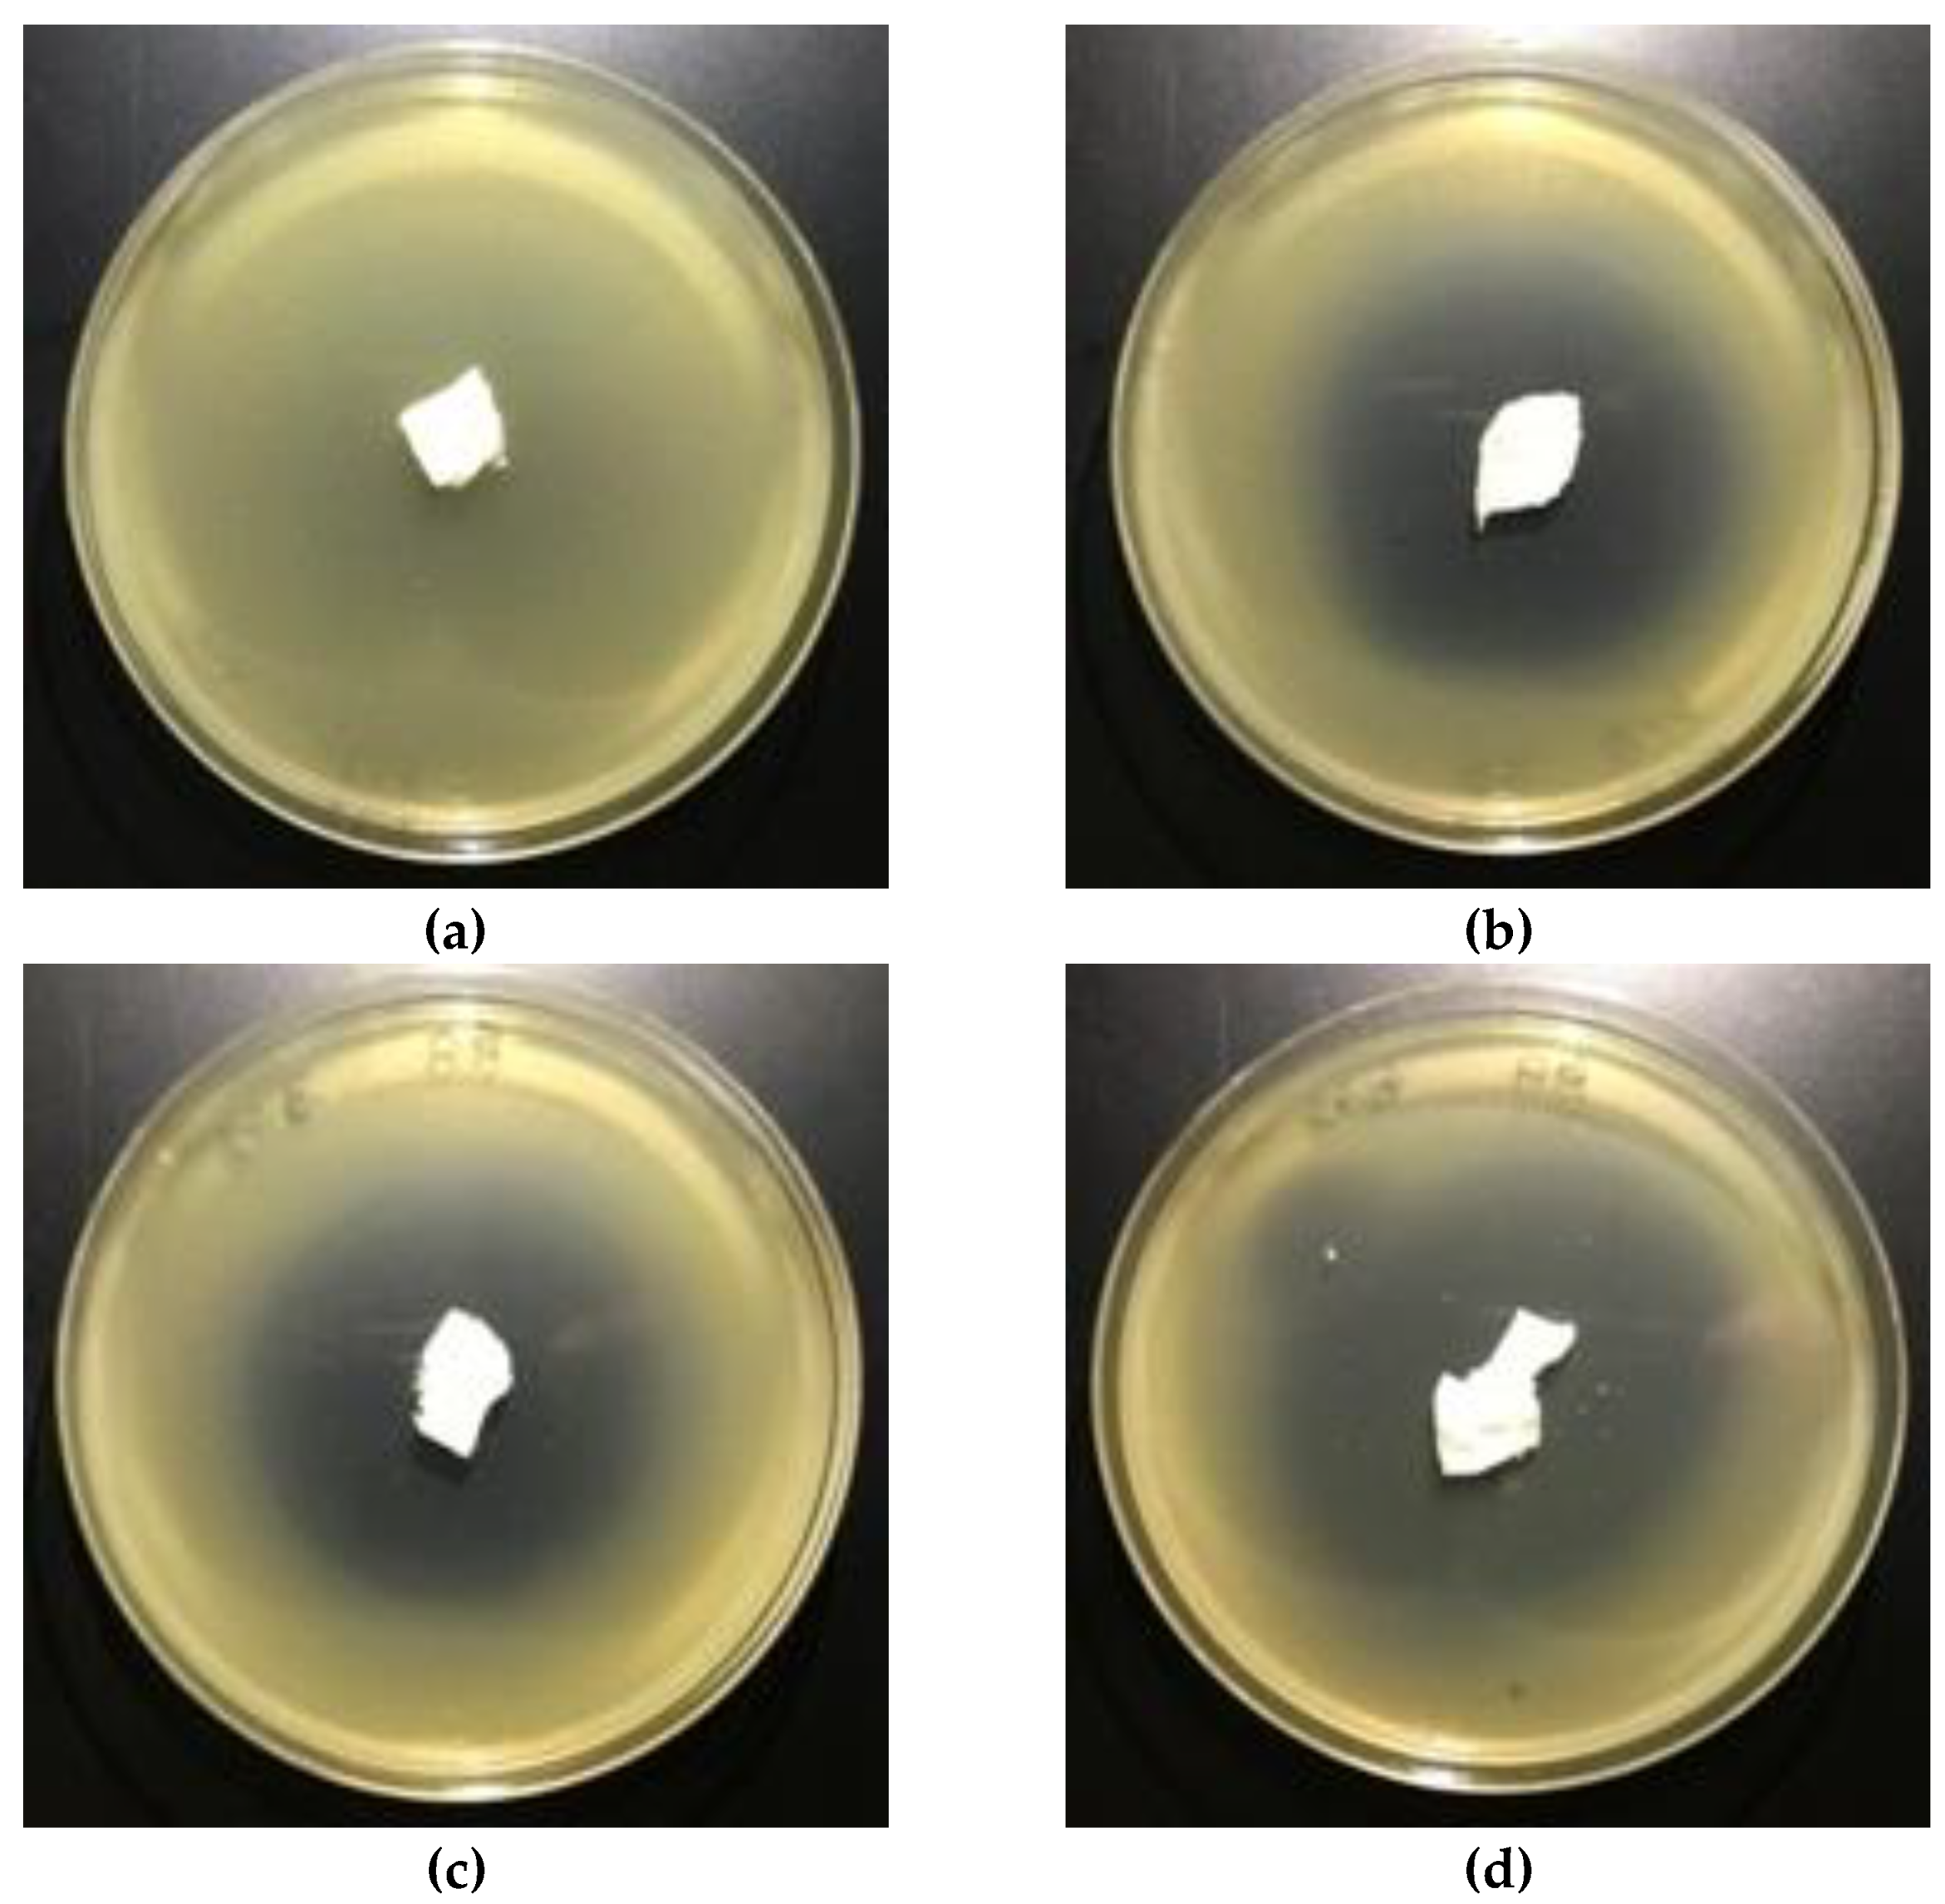
Polymers 12 00768 g009 Polymers 12 00768 g009

Biofunctionalization of Textile Materials. 2. Antimicrobial Modification of Poly(lactide) (PLA) Nonwoven Fabricsby Fosfomycin
Abstract
1. Introduction
2. Materials and Methods
2.1. Materials
2.1.1. Polymers
2.1.2. Chemical Agents
2.1.3. Finishing Agents
2.1.4. Bacterial Strains
2.2. Methods
2.2.1. Nonwoven Fabrics
2.2.2. Dip-Coating Modification of Poly(lactic acid) Nonwoven
2.2.3. SEM—Scanning Electron Microscopy
2.2.4. ATR-FTIR—Attenuated Total Reflection Fourier Transform Infrared Spectroscopy
2.2.5. UV-VIS Analysis
2.2.6. Filtration Parameters
2.2.7. Tensile Testing
2.2.8. Microbial Activity
3. Resultsand Discussion
3.1. Scanning Electron Microscopy
3.2. ATR-FTIR Spectra
3.3. UV/VIS Transmittance Spectra
3.4. Technical Parameters
3.5. Antimicrobial Activity
4. Conclusions
Author Contributions
Funding
Conflicts of Interest
References
- Auras, R.; Lim, L.T.; Selke, S.E.M.; Tsuji, H. (Eds.) Poly(Lactic Acid): Synthesis, Structures, Properties, Processing, and Applications; John Wiley & Sons, Inc.: Hoboken, NJ, USA, 2010. [Google Scholar]
- Gollwitzer, H.; Ibrahim, K.; Meyer, H.; Mittelmeier, W.; Busch, R.; Stemberger, A. Antibacterial poly(D,L-lactic acid) coating of medical implants using a biodegradable drug delivery technology. J. Antimicrob. Chemother. 2003, 51, 585–591. [Google Scholar] [CrossRef] [PubMed]
- Del Valle, L.J.; Camps, R.; Díaz, A.; Alfonso, L.F.; Rodríguez-Galán, A.; Puiggalí, J. Electrospinning of polylactide and polycaprolactone mixtures for preparation of materials with tunable drug release properties. J. Polym. Res. 2011, 18, 1903–1917. [Google Scholar] [CrossRef]
- Reise, M.; Wyrwa, R.; Müller, U.; Zylinski, M.; Voelpel, A.; Schnabelrauch, M.; Berg, A.; Jandt, K.D.; Watts, D.C.; Sigusch, B.W. Release of metronidazole from electrospun poly(l-lactide-co-d/l-lactide) fibers for local periodontitis treatment. Dent. Mater. 2012, 28, 179–188. [Google Scholar] [CrossRef]
- Qin, Y.; Yuan, M.; Li, L.; Li, W.; Xue, J. Formulation and evaluation of in situ forming PLA implant containing tinidazole for the treatment of periodontitis. J. Biomed. Mater. Res. B Appl. Biomater. 2012, 100, 2197–2202. [Google Scholar] [CrossRef]
- Torres-Giner, S.; Martinez-Abad, A.; Gimeno-Alcañiz, J.V.; Ocio, M.J.; Lagaron, J.M. Controlled delivery of gentamicin antibiotic from bioactive electrospun polylactide-based ultrathin fibers. Adv. Eng. Mater. 2012, 14, B112–B122. [Google Scholar] [CrossRef]
- Kau, Y.C.; Chen, D.W.C.; Hsieh, Y.T.; Lee, F.Y.; Liu, S.J. Compression molding of biodegradable drug-eluting implants for sustained release of metronidazole and doxycycline. J. Appl. Polym. Sci. 2013, 127, 554–560. [Google Scholar] [CrossRef]
- Zhou, J.; Han, S.; Dou, Y.; Lu, J.; Wang, C.; He, H.; Li, X.; Zhang, J. Nanostructured poly(l-lactide) matrix as novel platform for drug delivery. Int. J. Pharm. 2013, 448, 175–188. [Google Scholar] [CrossRef]
- Chen, S.; Wang, G.; Wu, T.; Zhao, X.; Liu, S.; Li, G.; Cui, W.; Fan, C. Silver nanoparticles/ibuprofen-loaded poly(L-lactide) fibrous membrane: Anti-infection and anti-adhesion effects. Int. J. Mol. Sci. 2014, 15, 14014–14025. [Google Scholar] [CrossRef]
- Pérez-Madrigal, M.M.; Llorens, E.; Del Valle, L.J.; Puiggali, J.; Armelin, E.; Alemán, C. Semiconducting, biodegradable and bioactive fibers for drug delivery. Express Polym. Lett. 2016, 10, 628–646. [Google Scholar] [CrossRef]
- Schkarpetkin, D.; Reise, M.; Wyrwa, R.; Völpel, A.; Berg, A.; Schweder, M.; Schnabelrauch, M.; Watts, D.C.; Sigusch, B.W. Development of novel electrospun dual-drug fiber mats loaded with a combination of ampicillin and metronidazole. Dent. Mater. 2016, 32, 951–960. [Google Scholar] [CrossRef]
- Yakub, G.; Toncheva, A.; Manolova, N.; Rashkov, I.; Danchev, D.; Kussovski, V. Electrospun polylactide-based materials for curcumin release: Photostability, antimicrobial activity, and anticoagulant effect. J. Appl. Polym. Sci. 2016, 133, 42940. [Google Scholar] [CrossRef]
- Herrera, M.T.; Artunduaga, J.J.; Ortiz, C.C.; Torres, R.G. Synthesis of antibiotic loaded polylactic acid nanoparticles and their antibacterial activity against Escherichia coli O157:H7 and methicillin-resistant Staphylococcus aureus. Biomedica 2017, 37, 11–21. [Google Scholar] [CrossRef] [PubMed]
- Karaszewska, A.; Kamińska, I.; Kiwała, M.; Gadzinowski, M.; Gosecki, M.; Słomkowski, S. Preparation and properties of textile materials modified with triclosan-loaded polylactide microparticles. Polym. Adv. Technol. 2017, 28, 1185–1193. [Google Scholar] [CrossRef]
- Shahi, R.G.; Albuquerque, M.T.P.; Münchow, E.A.; Blanchard, S.B.; Gregory, R.L.; Bottino, M.C. Novel bioactive tetracycline-containing electrospun polymer fibers as a potential antibacterial dental implant coating. Odontology 2017, 105, 354–363. [Google Scholar] [CrossRef]
- Han, C.; Cai, N.; Chan, V.; Liu, M.; Feng, X.; Yu, F. Enhanced drug delivery, mechanical properties and antimicrobial activities in poly(lactic acid) nanofiber with mesoporous Fe3O4-COOH nanoparticles. Colloids Surf. A Physicochem. Eng. Asp. 2018, 559, 104–114. [Google Scholar] [CrossRef]
- Cui, S.; Sun, X.; Li, K.; Gou, D.; Zhou, Y.; Hu, J.; Liu, Y. Polylactide nanofibers delivering doxycycline for chronic wound treatment. Mat. Sci. Eng. C 2019, 104, 109745. [Google Scholar] [CrossRef]
- Zhao, X.; Han, Y.; Zhu, T.; Feng, N.; Sun, Y.; Song, Z.; Li, S.; Liu, J.; Ding, J. Electrospun polylactide-nano-hydroxyapatite-vancomycin composite scaffolds for advanced osteomyelitis therapy. J. Biomed. Nanotechnol. 2019, 16, 1213–1222. [Google Scholar] [CrossRef]
- Davachi, S.M.; Kaffashi, B.; Zamanian, A.; Torabinejad, B.; Ziaeirad, Z. Investigating composite systems based on poly L-lactide and poly L-lactide/triclosan nanoparticles for tissue engineering and medical applications. Mater. Sci. Eng. C Mater. Biol. Appl. 2016, 58, 294–309. [Google Scholar] [CrossRef]
- Bertuoli, P.T.; Ordoño, J.; Armelin, E.; Pérez-Amodio, S.; Baldissera, A.F.; Ferreira, C.A.; Puiggalí, J.; Engel, E.; del Valle, L.J.; Alemán, C. Electrospun conducting and biocompatible uniaxial and core–shell fibers having poly(lactic acid), poly(ethylene glycol), and polyaniline for cardiac tissue engineering. ACS Omega 2019, 4, 3660–3672. [Google Scholar] [CrossRef]
- Chen, X.; Gao, C.; Jiang, J.; Wu, Y.; Zhu, P.; Chen, G. 3D printed porous PLA/nHA composite scaffolds with enhanced osteogenesis and osteoconductivity in vivo for bone regeneration. Biomed. Mater. 2019, 14, 065003. [Google Scholar] [CrossRef]
- Farzamfar, S.; Naseri-Nosar, M.; Sahrapeyma, H.; Ehterami, A.; Goodarzi, A.; Rahmati, M.; Lakalayeh, G.A.; Ghorbani, S.; Vaez, A.; Salehi, M. Tetracycline hydrochloride-containing poly (ε-caprolactone)/poly lactic acid scaffold for bone tissue engineering application: In vitro and in vivo study. Int. J. Polym. Mater. Polym. 2019, 68, 472–479. [Google Scholar] [CrossRef]
- Wang, H.; Wei, Q.; Wang, X.; Gao, W.; Zhao, X. Antibacterial properties of PLA nonwoven medical dressings coated with nanostructured silver. Fiber. Polym. 2008, 9, 556–560. [Google Scholar] [CrossRef]
- Liu, Y.; Liang, X.; Zhang, R.; Lan, W.; Qin, W. Fabrication of electrospun polylactic acid/ Cinnamaldehyde/β-cyclodextrin fibers as an antimicrobial wound dressing. Polymers 2017, 9, 464. [Google Scholar] [CrossRef]
- Foong, C.Y.; Hamzah, M.S.A.; Razak, S.I.A.; Saidin, S.; Nayan, N.H.M. Influence of poly(lactic acid) layer on the physical and antibacterial properties of dry bacterial cellulose sheet for potential acute wound healing materials. Fiber. Polym. 2018, 19, 263–271. [Google Scholar] [CrossRef]
- Vakilian, S.; Norouzi, M.; Soufi-Zomorrod, M.; Shabani, I.; Hosseinzadeh, S.; Soleimani, M.L. Inermis-loaded nanofibrous scaffolds for wound dressing applications. Tissue Cell 2018, 51, 32–38. [Google Scholar] [CrossRef]
- Moslem, Z.; Sadri, M.; Pebdeni, A.B. Antimicrobial and cellular activity of poly(L-lactide)/ chitosan/Imipenem antibiotic composite nanofibers. Fiber. Polym. 2016, 17, 1336–1342. [Google Scholar] [CrossRef]
- Li, W.; Yu, Q.; Yao, H.; Zhu, Y.; Topham, P.D.; Yue, K.; Ren, L.; Wang, L. Superhydrophobic hierarchical fiber/bead composite membranes for efficient treatment of burns. Acta Biomater. 2019, 92, 60–70. [Google Scholar] [CrossRef]
- Kukhar, V.P.; Hudson, H.R. (Eds.) Aminophosphonic and Aminophosphinic Acids. Chemistry and Biological Activity; Wiley&Sons Ltd.: New York, NY, USA, 2000. [Google Scholar]
- Parajuli, K.R.; Zhang, Q.; Liu, S.; You, Z. Aminomethylphosphonic acid inhibits growth and metastasis of human prostate cancer in an orthotopic xenograft mouse model. Oncotarget 2016, 7, 10616–10626. [Google Scholar] [CrossRef][Green Version]
- Parajuli, K.R.; Zhang, Q.; Liu, S.; You, Z. Aminomethyl phosphonic acid and methoxyacetic acid induce apoptosis in prostate cancer cells. Int. J. Mol. Sci. 2015, 16, 11750–11765. [Google Scholar] [CrossRef]
- Horiguchi, M.; Kandatsu, M. Isolation of 2-aminoethane phosphonic acid from rumen protozoa. Nature 1959, 184 (Suppl. 12), 901–902. [Google Scholar] [CrossRef]
- Tan, S.A.; Tan, L.G. Distribution of ciliatine (2-aminoethylphosphonic acid) and phosphonoalanine (2-amino-3-phosphonopropionic acid) in human tissues. Clin. Physiol. Biochem. 1989, 7, 303–309. [Google Scholar] [PubMed]
- Watts, M. Glufosinate-Ammonium Monograph. 2008. Available online: http://www.pananz.net/wp-content/uploads/2013/04/Glufosinate-monograph-12-Dec-2008.pdf (accessed on 18 June 2019).
- Franz, J.E.; Mao, M.K.; Sikorski, J.A. Glyphosate: A Unique Global Herbicide; American Chemical Society: Washington, DC, USA, 1997. [Google Scholar]
- Dill, G.M.; Sammons, R.D.; Feng, P.C.C.; Kohn, F.; Kretzmer, K.; Mehrsheikh, A.; Bleeke, M.; Honegger, J.L.; Farmer, D.; Wright, D.; et al. Glyphosate: Discovery, development, applications, and properties. In Glyphosate Resistance in Crops and Weeds. History, Development and Management; Nandula, V.K., Ed.; John Wiley& Sons, Inc.: Hoboken, NJ, USA, 2010. [Google Scholar] [CrossRef]
- Allen, J.G.; Atherton, F.R.; Hall, M.J.; Hassal, C.H.; Holmes, S.W.; Lambert, R.W.; Nisbet, L.J.; Ringrose, P.S. Phosphonopeptides, a new class of synthetic antibacterial agents. Nature 1978, 272, 56–58. [Google Scholar] [CrossRef] [PubMed]
- Allen, J.G.; Atherton, F.R.; Hall, M.J.; Hassall, C.H.; Holmes, S.W.; Lambert, R.W.; Nisbet, L.J.; Ringrose, P.S. Phosphonopeptides as antibacterial agents: Alaphosphin and related phosphono-peptides. Antimicrob. Agents Chemother. 1979, 15, 684–695. [Google Scholar] [CrossRef]
- Atherton, F.R.; Hall, M.J.; Hassall, C.H.; Lambert, R.W.; Lloyd, W.J.; Ringrose, P.S. Phosphonopeptides as antibacterial agents: Mechanism of action of alaphosphin. Antimicrob. Agents Chemother. 1979, 15, 696–705. [Google Scholar] [CrossRef]
- Atherton, F.R.; Hassall, C.H.; Lambert, R.W. Synthesis and structure-activity relationships of antibacterial phosphonopeptides incorporating (1-aminoethyl)phosphonic acid and (aminomethyl)-phosphonic acid. J. Med. Chem. 1986, 29, 29–40. [Google Scholar] [CrossRef]
- Lejczak, B.; Kafarski, P.; Sztajer, H.; Mastalerz, P. Antibacterial activity of phosphono dipeptides related to alafosfalin. J. Med. Chem. 1986, 29, 2212–2217. [Google Scholar] [CrossRef]
- Neu, H.C.; Kamimura, T. In vitro and in vivo antibacterial activity of FR-31564, a phosphonic acid antimicrobial agent. Antimicrob.Agents Chemother. 1981, 19, 1013–1023. [Google Scholar] [CrossRef]
- Jomaa, H.; Wiesner, J.; Sanderbrand, S.; Altincicek, B.; Weidemeyer, C.; Hintz, M.; Türbachova, I.; Eberl, M.; Zeidler, J.; Lichtenthaler, H.K.; et al. Inhibitors of the nonmevalonate pathway of isoprenoid biosynthesis as antimalarial drugs. Science 1999, 285, 1573–1576. [Google Scholar] [CrossRef]
- Wiesner, J.; Borrmann, S.; Jomaa, H. Fosmidomycin for the treatment of malaria. Parasitol. Res. 2003, 90 (Suppl. 2), S71–S76. [Google Scholar] [CrossRef]
- Zhang, B.; Watts, K.M.; Hodge, D.; Kemp, L.M.; Hunstad, D.A.; Hicks, L.M.; Odom, A.R. A second target of the antimalarial and antibacterial agent fosmidomycin revealed by cellular metabolic profiling. Biochemistry 2011, 50, 3570–3577. [Google Scholar] [CrossRef]
- Krishna, S.; Staines, H.M. Non-Antifolate Antibiotics: Clindamycin, Doxycycline, Azithromycin and Fosmidomycin. In Treatment and Prevention of Malaria. Milestones in Drug Therapy; Staines, H., Krishna, S., Eds.; Springer: Basel, Switzerland, 2011; Volume 41, pp. 141–156. [Google Scholar] [CrossRef]
- Jane, D. Neuroactive aminophosphonic and aminophosphinic acid derivatives. In Aminophosphonic and Aminophosphinic Acids. Chemistry and Biological Activity; Kukhar, V.P., Hudson, H.R., Eds.; Wiley& Sons Ltd.: New York, NY, USA, 2000; Chpt. 14; pp. 483–536. [Google Scholar]
- Cremers, S.; Drake, M.T.; Ebetino, F.H.; Bilezikian, J.P.; Russell, R.G.G. Pharmacology of bisphosphonates. Br. J. Clin. Pharmacol. 2019, 85, 1052–1062. [Google Scholar] [CrossRef] [PubMed]
- Cremers, S.; Papapoulos, S. Pharmacology of bisphosphonates. Bone 2011, 49, 42–49. [Google Scholar] [CrossRef]
- Rogers, M.J.; Gordon, S.; Benford, H.L.; Coxon, F.P.; Luckman, S.P.; Monkkonen, J.; Frith, J.C. Cellular and molecular mechanisms of action of bisphosphonates. Cancer 2000, 88 (Suppl. 12), 2961–2978. [Google Scholar] [CrossRef]
- Russell, R.G.G.; Croucher, P.I.; Rogers, M.J. Bisphosphonates: Pharmacology, mechanisms of action and clinical uses. Osteoporos. Int. 1999, 9 (Suppl. 2), S66–S80. [Google Scholar] [CrossRef]
- De Clercq, E.; Holý, A. Acyclic nucleoside phosphonates: A key class of antiviral drugs. Nat. Rev. Drug Discov. 2005, 4, 928–940. [Google Scholar] [CrossRef] [PubMed]
- De Clercq, E. A 40-year journey in search of selective antiviral chemotherapy. Annu. Rev. Pharmacol. Toxicol. 2011, 51, 1–24. [Google Scholar] [CrossRef] [PubMed]
- Patel, S.S.; Balfour, J.A.; Bryson, H.M. Fosfomycin Tromethamine. A Review of its antibacterial activity, pharmacokinetic properties and therapeutic efficacy as a single-dose oral treatment for acute uncomplicated lower urinary tract infections. Drugs 1997, 53, 537–656. [Google Scholar] [CrossRef]
- Falagas, M.E.; Giannopoulou, K.P.; Kokolakis, G.N.; Rafailidis, P.I. Fosfomycin: Use beyond urinary tract and gastrointestinal infections. Clin. Infect. Dis. 2008, 46, 1069–1077. [Google Scholar] [CrossRef] [PubMed]
- Falagas, M.E.; Vouloumanou, E.K.; Samonis, G.; Vardakas, K.Z. Fosfomycin. Clin. Microbiol. Rev. 2016, 29, 321–347. [Google Scholar] [CrossRef]
- Díez-Aguilar, M.; Cantón, R. New microbiological aspects of fosfomycin. Rev. Esp. Quimioter. 2019, 32 (Suppl. 1), 8–18. [Google Scholar]
- Gulcu, A.; Akman, A.; Demirkan, A.F.; Yorukoglu, A.C.; Kaleli, I.; Bir, F. Fosfomycin Addition to Poly(D,L-Lactide) Coating does not affect prophylaxis efficacy in rat implant-related infection model, but that of gentamicin does. PLoS ONE 2016, 11, e0165544. [Google Scholar] [CrossRef]
- Drabowicz, J.; Jakubowski, H.; Kudzin, M.H.; Kudzin, Z.H. Nomenclature of aminoalkylphosphonic acids and derivatives. Evolution of the code system. Acta Biochim. Pol. 2015, 62, 139–150. [Google Scholar] [CrossRef] [PubMed]
- Kudzin, Z.H.; Kudzin, M.H.; Drabowicz, J.; Stevens, C.V. Aminophosphonic acids-phosphorus analogues of natural amino acids. Part 1: Syntheses of α-aminophosphonic acids. Curr. Org. Chem. 2011, 15, 2015–2071. [Google Scholar] [CrossRef]
- Kudzin, Z.H.; Depczyński, R.; Kudzin, M.H.; Drabowicz, J. 1-(N-chloroacetylamino)-alkylphosphonic acids - Synthetic precursors of phosphonopeptides. Amino Acids 2008, 34, 163–168. [Google Scholar] [CrossRef] [PubMed]
- Kudzin, Z.H.; Kudzin, M.H.; Drabowicz, J. Thioureidoalkylphosphonates in the synthesis of 1-aminoalkylphosphonic acids. The Ptc-aminophosphonate method. Arkivoc 2011, 2011, 227–269. [Google Scholar] [CrossRef]
- Drabowicz, J.; Jordan, F.; Kudzin, M.H.; Kudzin, Z.H.; Stevens, C.V.; Urbaniak, P. Reactivity of aminophosphonic acids. Oxidative dephosphonylation of 1-aminoalkylphosphonic acids by aqueous halogens. Dalton Trans. 2016, 45, 2308–2317. [Google Scholar] [CrossRef]
- Sójka-Ledakowicz, J.; Chruściel, J.J.; Kudzin, M.H.; Łatwińska, M.; Kiwała, M. Antimicrobial functionalization of textile materials with copper silicate. Fibres Text. East. Eur. 2016, 24, 151–156. [Google Scholar] [CrossRef]
- Kudzin, M.H.; Mrozińska, Z.; Walawska, A.; Sójka-Ledakowicz, J. Biofunctionalization of textile materials.1. Biofunctionalization of poly(propylene) (PP) nonwovens fabrics by alafosfalin. Coatings 2019, 9, 412. [Google Scholar] [CrossRef]
- Jia, L.; Prabhakaran, M.P.; Qin, X.; Ramakrishna, S. Stem cell differentiation on electrospun nanofibrous substrates for vascular tissue engineering. Mater. Sci. Eng. C 2013, 33, 4640–4650. [Google Scholar] [CrossRef]
- Casasola, R.; Thomas, N.L.; Trybala, A.; Georgiadou, S. Electrospun poly lactic acid (PLA) fibres: Effect of different solvent systems on fibre morphology and diameter. Polymer 2014, 55, 4728–4737. [Google Scholar] [CrossRef]
- Gómez-Pachón, E.Y.; Vera-Graziano, R.; Campos, R.M. Structure of poly(lactic-acid) PLA nanofibers scaffolds prepared by electrospinning. IOP Conf. Ser. Mater. Sci. Eng. 2014, 59, 012003. [Google Scholar] [CrossRef]
- Piccirillo, G.; Bochicchio, B.; Pepe, A.; Schenke-Layland, K.; Hinderer, S. Electrospun poly-L-lactide scaffold for the controlled and targeted delivery of a synthetically obtained Diclofenac prodrug to treat actinic keratosis. Acta Biomater. 2017, 52, 187–196. [Google Scholar] [CrossRef] [PubMed]
- Yang, H.; Wang, L.; Xiang, C.; Li, L. Electrospun porous PLLA and poly(LLA-co-CL) fibers by phase separation. New J. Chem. 2018, 42, 5102. [Google Scholar] [CrossRef]
- Matysiak, W.; Kapica, A.; Tański, T.; Dubiel, A. Analysis of the influence of electro spinning process parameters on the morphology of poly(Lactic acid) fibres. Arch. Mater. Sci. Eng. 2019, 96, 73–78. [Google Scholar] [CrossRef]
- Krucińska, I.; Surma, B.; Chrzanowski, M.; Skrzetuska, E.; Puchalski, M. Application of melt-blown technology in the manufacturing of a solvent vapor-sensitive, non-woven fabric composed of poly(lactic acid) loaded with multi-walled carbon nanotubes. Text. Res. J. 2013, 83, 859–870. [Google Scholar] [CrossRef]
- Chrzanowska, O.; Struszczyk, M.H.; Krucinska, I. Small diameter tubular structure design using solvent-free textile techniques. J. Appl. Polym. Sci. 2014, 131, 40147. [Google Scholar] [CrossRef]
- Majchrzycka, K.; Brochocka, A.; Brycki, B. Biocidal agent for modification of poly(lactic acid) high-efficiency filtering nonwovens. Fibres Text. East. Eur. 2015, 23, 88–95. [Google Scholar] [CrossRef]
- Łatwińska, M.; Sójka-Ledakowicz, J.; Chruściel, J.; Piórkowski, M. PLA and PP composite nonwoven with antimicrobial activity for filtration applications. Int. J. Polym. Sci. 2016, 2016, 2510372. [Google Scholar] [CrossRef]
- Szuman, K.; Krucińska, I.; Boguń, M.; Draczyński, Z. PLA/PHA- biodegradable blends for pneumothermic fabrication of nonwovens. Autex Res. J. 2016, 16, 119–127. [Google Scholar] [CrossRef]
- Feng, J. Preparation and properties of poly(lactic acid) fiber melt blown non-woven disordered mats. Mater. Lett. 2017, 189, 180–183. [Google Scholar] [CrossRef]
- Yu, B.; Wang, M.; Sun, H.; Zhu, F.; Han, J.; Bhat, G. Preparation and properties of poly (lactic acid)/magnetic Fe3O4 composites and nonwovens. RSC Adv. 2017, 7, 41929–41935. [Google Scholar] [CrossRef]
- Vadas, D.; Kmetykó, D.; Marosi, G.; Bocz, K. Application of melt-blown Poly(lactic acid) fibres in self-reinforced composites. Polymers 2018, 10, 766. [Google Scholar] [CrossRef] [PubMed]
- Zhang, J.; Chen, G.; Bhat, G.S.; Azari, H.; Pen, H. Electret characteristics of melt-blown polylactic acid fabrics for air filtration application. J. Appl. Polym. Sci. 2020, 137, 48309. [Google Scholar] [CrossRef]
- Zhu, F.; Yu, B.; Su, J.; Han, J. Study on PLA/PA11 bio-based toughening melt-blown nonwovens. Autex Res. J. 2020, 20. in press. [Google Scholar] [CrossRef]
- Kister, G.; Cassanas, G.; Vert, M. Effects of morphology, conformation and configuration on the IR and Raman spectra of various poly( lactic acid)s. Polymer 1998, 39, 267–273. [Google Scholar] [CrossRef]
- Carstenn-Lichterfelde, C.; Fernandez-Ibanez, M.; Gálvez-Ruano, E.; Bellanato, J. Structural study of fosfomycin [(–)-cis-1,2-epoxypropylphosphonic acid] salts and related compounds. J. Chem. Soc. Perkin Trans. 2 1983, 943–947. [Google Scholar] [CrossRef]
- ENISO 20645. 2006–Textile Fabrics–Determination of Antibacterial Activity—Agar Diffusion Plate Test; International Organization for Standardization: Geneva, Switzerland, 2006. [Google Scholar]
- Jiang, L.; Wang, F.; Han, F.; Prinyawiwatkul, W.; No, H.K.; Ge, B. Evaluation of diffusion and dilution methods to determine the antimicrobial activity of water-soluble chitosan derivatives. J. Appl. Microbiol. 2012, 114, 956–963. [Google Scholar] [CrossRef]
- Balouiri, M.; Sadiki, M.; Ibnsouda, S.K. Methods for in vitro evaluating antimicrobial activity: A review. J. Pharm. Anal. 2016, 6, 71–79. [Google Scholar] [CrossRef]

| Name (Abbreviation) /a | Structure /b | Origin | Action/Application /c | Ref. |
|---|---|---|---|---|
| Phospho-glycine (GlyP) | ![]() | Primary PMG metabolite | Inhibition of prostate cancer cell growth (in vitro), phytotoxin | [30,31] |
| β-AlaP (β-phosphono-alanine, 2-AEP, ciliatine) | ![]() | The first and most abundant natural AAP | [32,33] | |
| Phosphino-thricin GluγP(Me) (phosphino-thricin, PPT) | ![]() | Produced by strains of Streptomyces herbicide | Inhibition of glutamine synthetase (E.C. 6.3.1.2) | [34] |
| PMG (Phosphono-Methyl-Glycine; Glyphosate) | ![]() | Artificial herbicide | inhibition of 5-enolpyruvyl-shikimic acid-3-phosphate synthase | [35,36] |
| Alafosfalin Ala-AlaP (alaphosphin; alafosfalin) | ![]() | Artificial antibiotic, against gram-negative and gram-positive bacteria. | selective inhibition of alanine racemase (EC 5.1.1.1). | [37,38,39,40,41] |
| Fosmidomycin ((3-(Formyl-hydroxy-amino)-propyl)-phosphonic acid; The phosphonate antibiotic FR-31564 | ![]() | Produced by strains of
Streptomyces A broad-spectrum antimicrobial agent | Inhibition of DXR (in vitro). A broad-spectrum antimicrobial agent currently applied for the malaria treatment. | [42,43,44,45,46] |
| ϖ-Aminoalkyl-phosphonic acids (ϖ-AAP) | ![]() | Artificial | Neuroactive acids | [47] |
| Aminoalkyl-bisphosphonic acids (ϖ-AAP,P) | ![]() X = H, OH, halogen | Artificial | Inhibition of osteoclastic bone resorption | [48,49,50,51] |
| Acyclic Nucleoside Phosphonates (ANPs) Cidovir [HPMPC] (B = Cyt; X = OH; R = H); Adefovir [PMEA] (B = Ade; X = H; R = POM); Tenovir [PMPA] (B = Ade; X = H; R = POC) | ![]() | Artificial | Treatment of various DNA virus infections (cidofovir), hepatitis B (adefovir), and AIDS (HIV infections, tenofovir) | [52,53] |
| Fosfomycin (phosphomycin/phosphono-mycin) | ![]() | Fosfomycin - a broad-spectrum antibiotic produced by Streptomyces species. | Oral UTIs treatment. provide a useful option for the treatment of patients with pathogens with advanced resistance infections. | [54,55,56,57,58] |
| Processing Parameters | |
|---|---|
| Temperature of the extruder in zone 1 | 195 °C |
| Temperature of the extruder in zone 2 | 245 °C |
| Temperature of the extruder in zone 3 | 260 °C |
| Head temperature | 260 °C |
| Air heater temperature | 260 °C |
| Air flow rate | 7–8 m³/h |
| Mass per unit area of nonwovens | 102 g/m2 |
| Polymer yields | 6 g/min |
| Components | g | % |
|---|---|---|
| styrene-acrylic resin | 6 | 6 |
| thickening agent | 1 | 1 |
| wetting agent | 3 | 3 |
| water | 90 | 90 |
| PLA [82] | |||||||||||
|---|---|---|---|---|---|---|---|---|---|---|---|
| IR [ν/cm−1]; Intensity | 2997; M | 2947; M | 1760; VS | 1452; S | 1348–1388; S | 1368–1360; S | 1270; S | 1215–1185; VS | 1130; S | 1100–1090; VS, sh | 1045; S |
| Assign- ment | νas CH3 | νs CH3 | ν C=O | δas CH3 | δs CH3 | δ1 CH + δs CH3 | δCH+ ν COC | νas COC +rasCH3 | rasCH3 | νs COC | ν C-CH3 |
| Fosfomycin (Fosfm) [83] | |||||||||||
| FosfmNa2 (Nujol) | |||||||||||
| IR [ν/cm−1]; Intensity | 3010 | 1414 w | 1270 w; 1260 w | 1125 s; 1096 vs | 1008 m | ||||||
| Assign- ment | ν(C–H) (ring) | δ (CH3) | Ring breath | νa (PO32−) | νa (PO32−) | ||||||
| FosfmCa × H2O (KBr) | |||||||||||
| IR [ν/cm−1]; Intensity | 3000 w | 1423 w; 1419 sh | 1262 vw | 1095 vs | 1017 m | ||||||
| Assign- ment | ν(C–H) (ring) | δ (CH3) | Ring breath | νa (PO32−) | νa (PO32−) | ||||||
| Parameter | PLA | PLA-Fosfomycin [% Fosfomycin paste concentr.] | |||
|---|---|---|---|---|---|
| 0.005% | 0.01% | 0.1% | |||
| Average air permeability [mm/s], pressure decrease: | 100 Pa | 910 | 442 | 440 | 449 |
| 200 Pa | 1677 | 880 | 876 | 891 | |
| Parameter | PLA | PLA-Fosfomycin [% fosfomycin paste concentr.] | ||
|---|---|---|---|---|
| 0.005% | 0.01% | 0.1% | ||
| Tensile strength[kN/m] | 0.032 | 0.117 | 0.120 | 0.115 |
| Relative elongation at maximum load [%] | 10.0 | 9.720 | 9.930 | 10.102 |
| Sample No. | Fosfomycinon PLAnonwovens | Bacterial Average Inhibition ZoneGrowth for Bacteria (mm) | |
|---|---|---|---|
| Fosfomycin Coating Pastes Concentrations (%) | E. coli | S. aureus | |
| 1 | 0 | 0 | 0 |
| 2 | 0.005 | 3–4 | 5 |
| 3 | 0.01 | 4–5 | 6 |
| 4 | 0.1 | 5–6 | 6 |
© 2020 by the authors. Licensee MDPI, Basel, Switzerland. This article is an open access article distributed under the terms and conditions of the Creative Commons Attribution (CC BY) license (http://creativecommons.org/licenses/by/4.0/).
Share and Cite
Kudzin, M.H.; Mrozińska, Z. Biofunctionalization of Textile Materials. 2. Antimicrobial Modification of Poly(lactide) (PLA) Nonwoven Fabricsby Fosfomycin. Polymers 2020, 12, 768. https://doi.org/10.3390/polym12040768
Kudzin MH, Mrozińska Z. Biofunctionalization of Textile Materials. 2. Antimicrobial Modification of Poly(lactide) (PLA) Nonwoven Fabricsby Fosfomycin. Polymers. 2020; 12(4):768. https://doi.org/10.3390/polym12040768
Chicago/Turabian StyleKudzin, Marcin H., and Zdzisława Mrozińska. 2020. "Biofunctionalization of Textile Materials. 2. Antimicrobial Modification of Poly(lactide) (PLA) Nonwoven Fabricsby Fosfomycin" Polymers 12, no. 4: 768. https://doi.org/10.3390/polym12040768
APA StyleKudzin, M. H., & Mrozińska, Z. (2020). Biofunctionalization of Textile Materials. 2. Antimicrobial Modification of Poly(lactide) (PLA) Nonwoven Fabricsby Fosfomycin. Polymers, 12(4), 768. https://doi.org/10.3390/polym12040768











